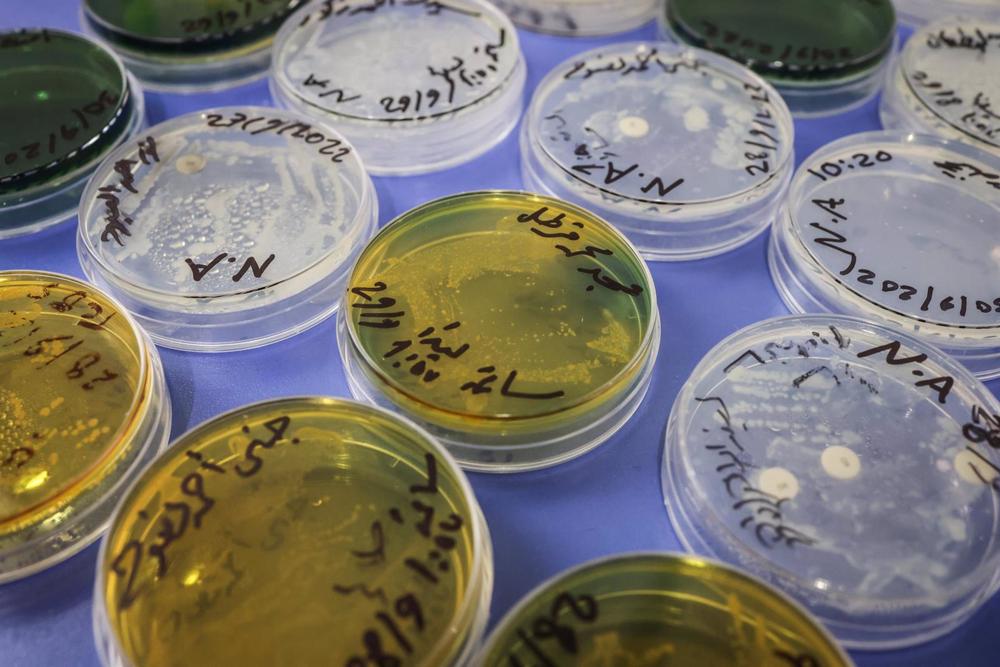
Archivio

Le autorità siriane hanno portato a più di 1.600 il numero di casi di colera rilevati dalla dichiarazione di un’epidemia a settembre, con epicentro nella provincia settentrionale di Aleppo, anche se si teme che la cifra possa essere molto più alta.
Il Ministero della Sanità siriano ha dichiarato che finora sono stati confermati 1.609 casi, con 49 decessi. Un totale di 987 casi è stato rilevato ad Aleppo, la provincia più colpita, come riportato dall’agenzia di stampa statale siriana SANA.
Le province più colpite sono Deir Ezzor con 233, Latakia con 97, Hasakah con 90, Raqqa con 54, Hama con 38, Homs con 28, Sueida con 26, Damasco con 20, Damasco campagna con 17, Tartous con dieci, Daraa con cinque e Quneitra con quattro.
Un totale di 40 morti è stato registrato ad Aleppo, mentre Hasakah ha confermato quattro morti, due a Deir Ezzor e uno ciascuno a Homs, Hama e Damasco.
La settimana scorsa le autorità siriane hanno lanciato una campagna di vaccinazione dopo aver ricevuto due milioni di dosi di vaccino. La campagna si rivolge principalmente alle popolazioni vulnerabili delle province più colpite dall’epidemia: Aleppo, Deir Ezzor, Hasakah e Raqqa.
Il rappresentante dell’Organizzazione Mondiale della Sanità (OMS) in Siria, Iman Shankiti, ha dichiarato prima del lancio della campagna che «il colera è una minaccia per la salute pubblica che colpisce la salute delle popolazioni e impone costi sostanziali ai sistemi sanitari pubblici».
Il colera è una malattia diarroica acuta causata dall’ingestione di cibo o acqua contaminati dal «bacillo vibrio cholerae», secondo quanto riportato dall’OMS sul suo sito web, dove si sottolinea che «il colera rimane una minaccia globale per la salute pubblica e un indicatore di iniquità e mancanza di sviluppo sociale».






